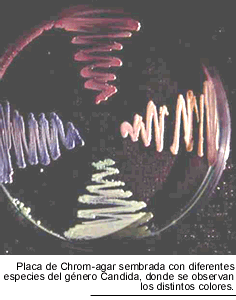

![]()
Candidiasis
 Las
candidiasis son las infecciones fúngicas más frecuentes en enfermos
con SIDA. La localización bucofaríngea se produce, según
las estadísticas, en el 40 a 90 % de los enfermos (13, 17, 27, 32, 36,
43). La candidiasis esofágica, que es considerada enfermedad marcadora,
presenta una incidencia estimada del 12 % (en el 6.7 %, el diagnóstico
es confirmado y en el 5.2 % es presuntivo). A diferencia de lo que sucede habitualmente,
la candidiasis bucal puede propagarse hacia el aparato respiratorio de los enfermos
HIV positivos. Sin embargo, su frecuencia es baja produciendo en el 3 % de ellos
traqueítis, bronquitis y neumonía (13, 43).
Las
candidiasis son las infecciones fúngicas más frecuentes en enfermos
con SIDA. La localización bucofaríngea se produce, según
las estadísticas, en el 40 a 90 % de los enfermos (13, 17, 27, 32, 36,
43). La candidiasis esofágica, que es considerada enfermedad marcadora,
presenta una incidencia estimada del 12 % (en el 6.7 %, el diagnóstico
es confirmado y en el 5.2 % es presuntivo). A diferencia de lo que sucede habitualmente,
la candidiasis bucal puede propagarse hacia el aparato respiratorio de los enfermos
HIV positivos. Sin embargo, su frecuencia es baja produciendo en el 3 % de ellos
traqueítis, bronquitis y neumonía (13, 43).
Las candidiasis diseminadas
son poco frecuentes, y cuando se presentan, existen otros factores predisponentes
diferentes del HIV. Estos son catéteres venosos colocados por tiempo
prolongado, catéteres centrales, neutropenia o aplasias medulares (por
drogas o invasión por otras infecciones), hiperalimentación parenteral,
administración de antibióticos y citostásicos. La drogadicción
parenteral entre estos enfermos ha provocado un incremento de la endocarditis
infecciosas debidas a Candida en las cavidades derechas (36).
Los hongos del género
Candida son integrantes normales de la biota del tubo digestivo, su homeostasis
con el organismo humano es compleja y depende de muchos factores, entre ellos
la inmunidad mediada por células desempeña un papel destacado.
La dupla linfocitos CD4-macrófago ejerce un poder de vigilancia en la
superficie de las membranas mucosas y la piel. Su déficit provoca una
mayor facilidad de los hongos del género Candida para adherirse a las
células epiteliales, por medio de sus tubos germinativos, iniciando así
su acción patógena. La frecuencia y gravedad de estas infecciones
dependen, sobretodo, del nivel de células CD4 positivas en sangre. Las
candidiasis comienzan a hacerse evidentes en enfermos con recuentos inferiores
a los 400 linfocitos CD4/µl (11,66).
Debe tenerse en cuenta que
los mananos y las mananoproteinas de la pared celular de Candida son activadoras
de las células CD8 y deprimen la actividad de las CD4, potenciando, de
esta forma, el efecto inmunodepresor del HIV. Por esta razón se ha propuesto
la administración de tratamientos antifúngicos durante lapsos
prolongados, a fin de reducir el nivel de antígenos libres en la sangre
y los tejidos, evitando así un deterioro mayor de la inmunidad (66, 69).
La preservación de
la función fagocitaria de los polimorfonucleares neutrófilos en
los pacientes HIV positivos, así como la buena producción de anticuerpos
contra el antígeno de 47 KDa de Candida, explica la baja frecuencia de
candidiasis diseminadas en condiciones habituales (66).
Los estudios epidemiológicos,
empleando la caracterización del ADN de las cepas de Candida, han demostrado
que las fuentes de infección para los pacientes son tanto endógenas
como exógenas. En estas últimas, la portación de levaduras
por parte del personal de salud tiene una especial importancia. Sin embargo,
en una investigación realizada en nuestro medio, pudo comprobarse que
la mayor parte de las candidiasis orofaríneas en pacientes con SIDA,
era de origen endógeno (25).
La
distribución geográfica de esta micosis es universal, y más
de 70 % de ellas son producidas por C. albicans (7, 66). Se observa un porcentaje
mayor de lo usual de candidiasis por C. albicans serotipo B (37 a 42 % de los
casos), habitualmente resistentes a la 5-fluorocitosina.
La aplicación del sistema "killer' ha permitido comprobar que el
tipo 377 es el más frecuentemente observado. Las otras especies productoras
de infecciones son C. tropicalis, C. stellatoidea, C. parapsilosis, C. krusei
y C. (Torulopsis) glabrata. Estas dos últimas son habitualmente resistentes
a los compuestos azólicos y su hallazgo como agentes de infecciones ha
aumentado en los últimos años, como consecuencia del empleo masivo
de estos antifúngicos (34, 36, 66). En 1995 se descubrió una nueva
especie, Candida dubliniensis, que produce clamidosporos, tubos germinativos
y colonias de color verde en CHROM-agar, pero posee caracteres genotípicos
(de su ADN) diferentes de los de Candida albicans (7, 58). Esta nueva especie
produce mayor número de clamidosporos y un color verde más intenso
en CHROM-agar, determina, además, fermentaciones de carbohidratos diferentes
a las de C. albicans. Sin embargo, el único procedimiento seguro de diagnóstico
es la cariotipificación (58).
La
distribución geográfica de esta micosis es universal, y más
de 70 % de ellas son producidas por C. albicans (7, 66). Se observa un porcentaje
mayor de lo usual de candidiasis por C. albicans serotipo B (37 a 42 % de los
casos), habitualmente resistentes a la 5-fluorocitosina.
La aplicación del sistema "killer' ha permitido comprobar que el
tipo 377 es el más frecuentemente observado. Las otras especies productoras
de infecciones son C. tropicalis, C. stellatoidea, C. parapsilosis, C. krusei
y C. (Torulopsis) glabrata. Estas dos últimas son habitualmente resistentes
a los compuestos azólicos y su hallazgo como agentes de infecciones ha
aumentado en los últimos años, como consecuencia del empleo masivo
de estos antifúngicos (34, 36, 66). En 1995 se descubrió una nueva
especie, Candida dubliniensis, que produce clamidosporos, tubos germinativos
y colonias de color verde en CHROM-agar, pero posee caracteres genotípicos
(de su ADN) diferentes de los de Candida albicans (7, 58). Esta nueva especie
produce mayor número de clamidosporos y un color verde más intenso
en CHROM-agar, determina, además, fermentaciones de carbohidratos diferentes
a las de C. albicans. Sin embargo, el único procedimiento seguro de diagnóstico
es la cariotipificación (58).
La candidiasis bucofaríngea se presenta, habitualmente, bajo la forma seudomembranosa, conocida en nuestro medio como "muguet". Los pacientes refieren pérdida de la sensación gustativa, ardor, disfagia alta y sialorrea. Con menor frecuencia se observa la forma atrófica eritematosa o estomatitis hipertróficas con macroglosia, lengua escrotal (fisurada), gingivitis, hemorragias frecuentes de las encías y queilitis angular. Esta última manifestación puede observarse acompañando a cualquier tipo de estomatitis candidiásica.
Estas lesiones tienen una
tendencia recidivante muy marcada. Si bien su aspecto clínico es muy
característico, el diagnóstico debe ser siempre confirmado por
el estudio micológico, ya que pueden confundirse con infecciones bacterianas,
lesiones herpéticas y la leucoplasia vellosa producida por el virus de
Epstein-Barr.
El examen microscópico
directo de las seudomembranas en preparaciones al estado fresco con KOH al 10
% o en extendidos teñidos con la técnica de Gram, permite demostrar
la presencia de seudohifas y blastoconidias. Los cultivos se llevan a cabo en
medio de Sabouraud y pueden hacerse en forma cualitativa o cuantitativa. Para
esta última se le indica al enfermo que haga un buche con 10 ml de agua
destilada estéril durante 15 segundos. Luego, el contenido bucal es volcado
sobre una placa de Petri y se hacen diluciones de 1 x 10-1, 1 x 10-2 y 1 x 10-3.
Seguidamente, se siembra 1 ml de cada dilución por duplicado, en cajas
de Petri con medio de Sabouraud adicionado de cloranfenicol y estreptomicina.
El recuento se lleva a cabo a las 48 horas de incubación a 30º C.
En general, la candidiasis con lesiones clínicamente evidentes presentan
recuentos superiores a 1000 unidades formadoras de colonias (UFC) por ml. Los
enfermos HIV positivos sin candidiasis muestran recuentos superiores a las 400
UFC/ml (7, 45, 66).
Es aconsejable la siembra directa en CHROM-agar cuando la economía de la Institución lo permita. Este procedimiento tiene la ventaja de permitir un recuento de colonias como el ya relatado y, además, la detección de infecciones producidas por más de una especie de Candida. En nuestra experiencia esto sucede en alrededor del 12 % de los pacientes (4).
 La
candidiasis esofágica es la segunda localización en orden de frecuencia
y la causa más común de esofagitis en los pacientes infectados
por el HIV. Como ya señalamos, es considerada una enfermedad marcadora.
Los casos sintomáticos producen dolor retroesternal y disfagia, pero
hay casos sin síntomas, en los que sólo la endoscopía muestra
lesiones. La radiografía contrastada de esófago presenta defectos
de relleno, ocasionados por las múltiples ulceraciones superficiales
de la mucosa. Su aspecto es muy característico, llamado esófago
en empedrado, aunque no es patognomónico, porque puede ser producido
por el Herpes simplex y por aftas. La exploración endoscópica
del esófago, aunque no es realizada sistemáticamente, es indispensable
para el diagnóstico de certeza, ya que permite reconocer las seudomembranas
y tomar biopsias (11, 43, 66). La observación microscópica de
seudohifas en las biopsias de la mucosa esofágica es el único
argumento seguro de diagnóstico. Habitualmente, un paciente que refiere
síntomas de esofagitis y tiene candidiasis bucofaríngea, es tratado
empíricamente y, sólo si no responde, es sometido a la esofagoscopía
y a los estudios histopatológicos y micológicos. Los hongos del
género Candida pueden complicar las lesiones esofágicas de otro
origen como las aftas, las herpéticas y las producidas por el Citomegalovirus.
La
candidiasis esofágica es la segunda localización en orden de frecuencia
y la causa más común de esofagitis en los pacientes infectados
por el HIV. Como ya señalamos, es considerada una enfermedad marcadora.
Los casos sintomáticos producen dolor retroesternal y disfagia, pero
hay casos sin síntomas, en los que sólo la endoscopía muestra
lesiones. La radiografía contrastada de esófago presenta defectos
de relleno, ocasionados por las múltiples ulceraciones superficiales
de la mucosa. Su aspecto es muy característico, llamado esófago
en empedrado, aunque no es patognomónico, porque puede ser producido
por el Herpes simplex y por aftas. La exploración endoscópica
del esófago, aunque no es realizada sistemáticamente, es indispensable
para el diagnóstico de certeza, ya que permite reconocer las seudomembranas
y tomar biopsias (11, 43, 66). La observación microscópica de
seudohifas en las biopsias de la mucosa esofágica es el único
argumento seguro de diagnóstico. Habitualmente, un paciente que refiere
síntomas de esofagitis y tiene candidiasis bucofaríngea, es tratado
empíricamente y, sólo si no responde, es sometido a la esofagoscopía
y a los estudios histopatológicos y micológicos. Los hongos del
género Candida pueden complicar las lesiones esofágicas de otro
origen como las aftas, las herpéticas y las producidas por el Citomegalovirus.
Los exámenes endoscópicos
del aparato respiratorio superior han puesto en evidencia la propagación
de las infecciones por Candida hacia la laringe, traquea y bronquios. En las
mucosas se observan seudomembranas sobre una base eritematosa y congestiva.
Es una de las causas de tos, uno de los síntomas más frecuentes
en los pacientes infectados por el HIV. De cualquier forma, debe tenerse en
cuenta que su frecuencia es baja, menor al 3 %. Los estudios de autopsia han
permitido comprobar que pueden también producir neumonitis (66, 69).
La colonización del
intestino por hongos del género Candida es habitual en los pacientes
con SIDA. Los recuentos de colonias de levaduras en muestras de materia fecal
están elevados en más del 70 % de los casos. La aparición
de diarrea, acompañada o no de fiebre en estos enfermos es muy común,
pero resulta muy difícil establecer el papel que desempeñan estos
hongos en la producción del cuadro clínico, dada la multiplicidad
de agentes microbianos que pueden provocarlo (43, 66).
La frecuencia y gravedad de las candidiasis vaginales en las pacientes HIV positivas, ha sido motivo de controversia. Las primeras investigaciones indicaron que la candidiasis vaginal era frecuente en las mujeres infectadas por HIV. Los estudios arrojaron que esta infección vaginal se producía con recuentos de linfocitos CD4 inferiores a los 300/ µL, y que su aparición debía hacer sospechar de la existencia de una infección por el retrovirus de la inmunodeficiencia humana. Sin embargo, estos trabajos carecían de un estudio similar en una población control, constituída por mujeres de la misma edad. Cuando estos estudios se llevaron a cabo, se pudo demostrar que la frecuencia de la candidiasis vaginal no era superior en las mujeres HIV positivas. A pesar de esto, existe un riesgo mayor de recaídas. El 75 % de las mujeres en edad reproductiva, presenta algún episodio de vulvovaginitis por Candida y el 33 % tiene episodios reiterados. Los síntomas son los habituales: prurito, sensación urente, disuria y dispareunia (72).
Las candidiasis ungueales
y cutáneas no son más frecuentes en los pacientes seropositivos.
Se establece así una diferencia nítida con la candidiasis mucocutánea
crónica, afección que también se origina por deficiencia
de la inmunidad mediada por células y en donde el compromiso cutáneo
y ungueal es casi constante (43).
 Las
candidiasis diseminadas son observadas en aproximadamente el 1 % de los enfermos
con SIDA avanzado, raras veces son diagnosticadas por los hemocultivos positivos
y, con menor frecuencia, el hallazgo de seudohifas o elementos levaduriformes
en el examen microscópico de la capa de leucocitos, han permitido su
reconocimiento. Para este último examen, la capa de leucocitos es separada
de una muestra de sangre con anticoagulante y se realizan extendidos que se
tiñen con el método Giemsa (45).
Las
candidiasis diseminadas son observadas en aproximadamente el 1 % de los enfermos
con SIDA avanzado, raras veces son diagnosticadas por los hemocultivos positivos
y, con menor frecuencia, el hallazgo de seudohifas o elementos levaduriformes
en el examen microscópico de la capa de leucocitos, han permitido su
reconocimiento. Para este último examen, la capa de leucocitos es separada
de una muestra de sangre con anticoagulante y se realizan extendidos que se
tiñen con el método Giemsa (45).
El cuadro clínico es poco característico, y constituye una de las causas de fiebre de origen desconocido. Las autopsias han demostrado que las localizaciones más frecuentes son los pulmones, el esófago, los riñones, el hígado, el bazo y el intestino delgado. Tanto la búsqueda de anticuerpos específicos, como de antígenos de Candida en el suero sanguíneo han proporcionado resultados inciertos y poco específicos, no son, en consecuencia, reacciones recomendables para la identificación de la candidiasis diseminada en enfermos HIV positivos (66).
La aparición de endocarditis
infecciosas en la válvula tricuspidea, es un hecho relativamente frecuente
en los adictos a drogas por vía venosa. Las causas más comunes
son Staphylococcus aureus, S. epidermidis y Candida parapsilosis. El cuadro
clínico se caracteriza por fiebre, soplo cardíaco, insuficiencia
cardíaca derecha y tromboembolismo pulmonar. La ecocardiografía
bidimensional y transesofágica permite el reconocimiento de las vegetaciones
que, cuando son de gran tamaño, incrementan la sospecha de endocarditis
fúngica.
El diagnóstico puede
confirmarse mediante los hemocultivos con la técnica de lisis-centrifugación
y la contrainmunoelectroforesis, empleando un antígeno citoplasmático
de Candida (3).
El tratamiento de las candidiasis
bucofaríngeas y esofágicas se lleva a cabo con compuestos azólicos.
Por lo habitual se indica fluconazol a razón de 100 a 200 mg/día,
durante 1 semana en las estomatitis y por 2 semanas en los casos de localización
esofágica, empleando cápsulas o solución oral (2, 36, 45,
66). En los casos de localización esofágica puede recurrirse al
tratamiento intravenoso o al empleo de la solución oral, cuando la odinofagia
es extrema. También ha sido utilizado con mucho éxito el itraconazol
en solución con hidroxipropilciclodextrina (10 mg/ml) (7, 26). Se indican
las mismas dosis que de fluconazol y su efecto es doble, local y sistémico,
por su buena absorción digestiva. Esta forma farmacéutica del
itraconazol es mucho más eficaz que las cápsulas para el tratamiento
de estas afecciones, ya que su absorción digestiva es mucho más
regular, aún en presencia de lesiones del tubo digestivo. La indicación
fundamental de la solución de itraconazol es el tratamiento de las candidiasis
orofaríngeas y esofágicas refractarias al fluconazol, en donde
ha mostrado una eficacia variable entre el 54 % y 61 % de los casos tratados.
Las infecciones producidas por C. krusei y C. glabrata responden mejor al itraconazol
(65).
Se ha empleado, con buenos
resultados, un gel oral de miconazol. La acción de este imidazólico
es sobretodo local, dado que su absorción digestiva es mínima
(menor del 20 %). Se indica realizar buches con 5 ml del gel, 4 veces por día,
durante 2 semanas. El buche es luego deglutido para que actúe en el esófago.
La tolerancia es buena y produce un alivio rápido a los enfermos.
La resistencia de estas infecciones a los compuestos azólicos es un problema de creciente importancia, especialmente frente al fluconazol. Se define como resistencia clínica a la falta de respuesta al tratamiento con 200 mg/día durante 1 semanas con fluconazol (7). Los estudios de susceptibilidad "in vitro" realizados de acuerdo al documento M 27 A, han demostrado que las CIM <a 8µg/mL corresponden a cepas sensibles, las de 8 a 16 µg/mL corresponden a cepas de susceptibilidad intermedia y las >a 32 µg/mL son consideradas resistentes. Estos niveles de sensibilidad "in vitro" han demostrado una buena relación con las respuestas clínicas (7, 38, 53). Los portadores de cepas consideradas resistentes no deben ser tratados con fluconazol, las de sensibilidad intermedia responden clínicamente a dosis superiores a las usuales y las sensibles presentan buena respuesta clínica a las dosis diarias de fluconazol antes señaladas. Se ha podido demostrar que no es frecuente la resistencia cruzada entre los azólicos, 85 % de las cepas resistentes al fluconazol fueron sensibles al itraconazol y al ketoconazol, por otra parte, más del 60 % de los casos que no respondieron clínicamente al fluconazol, mejoraron con la administración de la solución oral de itraconazol (26). Pese a la importancia de estos hallazgos de la susceptibilidad "in vitro", debe tenerse en cuenta que la falta de respuesta clínica al fluconazol, es un hecho complejo que depende también de factores del huésped. El riesgo aumenta en pacientes con recuentos de linfocitos CD4 < 50/µL, en los que hayan tenido episodios previos de candidiasis bucofaríngea y en los que hayan recibido tratamientos prolongados con fluconazol. Hay que considerar, además, la posibilidad de interacciones con otras drogas y las fallas de absorción (2).
 El
empleo frecuente de compuestos azólicos ha dado origen a superinfecciones
por especies resistentes como C. krusei y C. glabrata.
El
empleo frecuente de compuestos azólicos ha dado origen a superinfecciones
por especies resistentes como C. krusei y C. glabrata.
Los fracasos terapéuticos
han sido la causa por la cual, en la actualidad, se hace identificación
de género y especie de Candida en la mayor parte de los casos. Para cumplir
con este propósito, en la Unidad Micología del Hospital Muñiz,
realizamos aislamiento de colonias y sembramos en un medio de cultivo con agar,
1 % de leche y 1 % de Tween 80. En este medio, a las 3 horas de incubación
a 37º C, se observan tubos germinativos y a las 48 horas clamidosporos,
si el microorganismo aislado es C. albicans o Candida dubliniensis. En caso
negativo la identificación de las restantes especies del género
se realiza por CHROM-agar, API 20 C y API 32 C. Inclusive, ha sido propuesto
el empleo de CHROM-agar adicionado de dosis crecientes de fluconazol para detectar
cepas resistentes a este fármaco (4, 53).
La determinación
de la sensibilidad "in vitro" de la cepa aislada a los compuestos
azólicos no es realizada rutinariamente, pero debe llevarse a cabo en
los pacientes que presenten reiterados episodios de candidiasis bucofaríngeas
o esofágicas. Estas determinaciones son realizadas en centros de referencia.
Las recaídas post-tratamiento
se observan en más del 85 % de los casos, y obliga al uso de antifúngicos
por períodos muy prolongados. Pese a ello, no se aconseja la implementación
de profilaxis primaria en pacientes con bajos recuentos de linfocitos CD4 y
la profilaxis secundaria queda a criterio del médico tratante. Tanto
una como otra han demostrado ser eficaces, pero elevan mucho el costo del tratamiento
y aumentan los riesgos de efectos tóxicos e interacción de drogas
(16).
Cuando la falta de respuesta
o la interacción con otras drogas tornan inútil o imposible el
empleo de azólicos, puede recurrirse al uso de la suspensión oral
de nistatina, a razón de 2 millones de unidades cada 6 horas. En casos
extremos se ha utilizado la anfotericina B para el tratamiento de la esofagitis
por Candida. Esta última droga está indicada en el tratamiento
de las endocarditis y las candidiasis sistémicas, la dosis diaria recomendada
es 0.7 mg/kg/día, y la total es de aproximadamente 1.200 a 1.500 mg.
El uso del tratamiento antirretroviral de alta eficacia ha reducido la frecuencia de candidiasis digestiva, tanto en lo relativo al ataque primario como a las recidivas. Este afecto es más notable en los países industrializados donde estos tratamientos están al alcance de un mayor número de infectados (24).
![]()